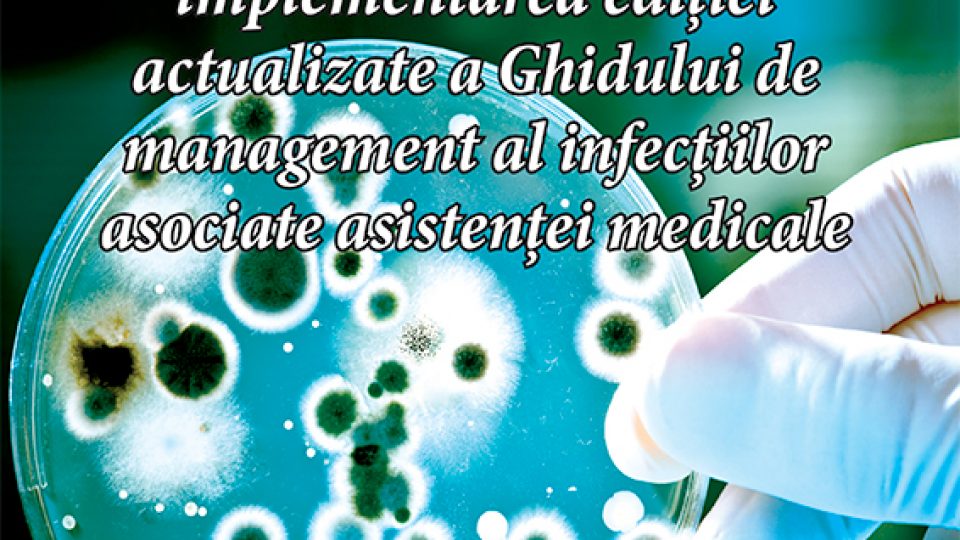
conferinta infectii octombrie 2016

Category: Conferințe
03
APR
2017
APR
2017
A doua conferinta "Managementul riscului clinic - componenta esentiala a sigurantei pacientului in unitatile sanitare" va avea loc pe 20.04.2017 in Bucuresti la hotel Golden Tulip Times (bd. Decebal nr. 19, sector 3).
Puteti accesa agenda si formularul de inscriere mai jos:
-descarcă AGENDA CONFERINȚEI
-descarcă FORMULARUL DE ÎNSCRIERE
28
MAR
2017
MAR
2017
S-au incheiat inscrierile la Conferinta "Managementul riscului clinic - componenta esentiala a sigurantei pacientului in unitatile sanitare" din 7-9 aprilie.
Intrucat primim numeroase solicitari si dupa expirarea termenului de inscriere anuntat initial, am hotarat sa organizam o a doua editie, pe aceeasi tema, care se va desfasura in data de 20.04.2017 ... mai mult
14
MAR
2017
MAR
2017
Fundaţia Amfiteatru organizează și are onoarea să vă invite la Conferința de lansare a Ghidului de management al Infecțiilor Asociate Asistenței Medicale, 27 - 29 aprilie 2017, Târgu Mureș
Partener instituțional: Autoritatea Națională de Management al Calității în Sănătate... mai mult
21
FEB
2017
FEB
2017
Fundaţia Amfiteatru organizează și are onoarea să vă invite la Conferința „Managementul riscului clinic -componentă esențială a siguranței pacientului în unitățile sanitare”, care va avea loc in perioada 7-9 aprilie 2017 la Hotel Golden Tulip Times, bld. Decebal nr.19, sector 3, București.
Partener instituțional: Autoritatea Națională de Management ... mai mult
31
IAN
2017
IAN
2017
În perioada 26-28 ianuarie 2017 s-a desfășurat la Iași Conferința de consens național privind implementarea ediției actualizate a Ghidului de management al Infectiilor Asociate Asistentei Medicale (IAAM).
Evenimentul a fost organizat de Fundația Amfiteatru în parteneriat cu Autoritatea Națională de Management al Calității în Sănătate și cu ... mai mult
28
NOV
2016
NOV
2016
Fundația Amfiteatru, în parteneriat cu Autoritatea Națională de Management al Calității în Sănătate, organizează cea de a VI-a Conferință de consens național privind managementul infecțiilor asociate actului medical, cu scopul de a pune în acord opiniile experților și punctul de vedere al practicienilor pe acest subiect de importanță ... mai mult
18
IUL
2016
IUL
2016
In perioada 30 iunie - 2 iulie 2016 a avut loc, la Târgu-Mureș, conferința cu tema “Actualizarea Ghidului de management al infecțiilor nosocomiale”, organizată de Fundația Amfiteatru în colaborare ... mai mult
08
MAI
2015
MAI
2015
Fundatia Amfiteatru si Asociatia Romana de Turism Medical organizeaza Conferinta Nationala cu Participare Internationala “Inovatie si calitate in asistenta medicala de specialitate”, Editia I “Calitate si inovatie in ortopedie, traumatologie si imagistica medicala”, Bucuresti, Hotel Ibis Palatul Parlamentului, 20 – 22 noiembrie 2015. Evenimentul se desfasoara sub egida Clusterului Medical ... mai mult
04
MAI
2015
MAI
2015
Fundatia Amfiteatru si Asociatia Romana de Turism Medical, organizeaza Conferinta Regionala de Oncologie, editia I “Inovatie in oncologie”, Bucuresti, Hotel Ambasador, 15 Mai 2015. Evenimentul se desfasoara sub egida Clusterului Medical “Sanatate Romania”.
Evenimentul isi stabileste drept principal obiectiv promovarea inovatiei in domeniul oncologiei, prezentarile si dezbaterile ... mai mult
27
IUL
2023
IUL
2023
Elaborarea și implementarea protocoalelor de diagnostic și tratament – Constanța, Târgu-Mureș, Iași ...
24
APR
2023
APR
2023
Conferința de consens național privind elaborarea și implementarea ediției a III-a – revizuită și actualizată a Ghidului de management al Infecțiilor Asociate Asistenței Medicale, Târgu Mureș, 15 - 17 iunie 2023 – eveniment creditat de către Colegiul Medicilor din România cu 17 credite EMC ...
12
DEC
2022
DEC
2022
Informare Conferința „Managementul calității serviciilor de sănătate – provocări și oportunități” – 8 decembrie 2022, București ...